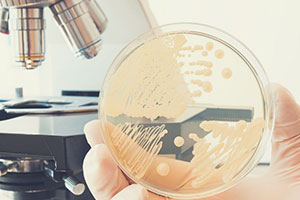

Кандидоз ногтей и вич
Кандидоз — это одна из грибковых инфекций, вызванная грибком рода Candida. Кандидоз при ВИЧ может протекать интенсивнее и нести прямую угрозу жизни. В умеренном количестве в микрофлоре каждого здорового человека есть этот грибок. Некоторые люди являются активными переносчиками грибка, при этом не ощущая никакого дискомфорта. Но патология у ВИЧ-инфицированных имеет явные проявления и может стать причиной летального исхода. У предположительно здорового человека он может быть признаком ВИЧ-инфекции.

Причины развития
Грибок рода Кандида есть у всех, но болезней либо патологий он может не вызывать у здорового человека с достаточной сопротивляемостью организма. Спровоцировать развитие может ослабление защитной функции организма (местный иммунодефицит) либо же вирус иммунодефицита человека (ВИЧ). Поэтому орофарингеальный кандидоз (поражает слизистую носоглотки), который проявляется на первых стадиях у 90% ВИЧ-инфицированных, считают одним из маркеров смертельной болезни.
Candida albicans проявляется не только при СПИДе. Даже те штаммы и проявления грибка, которые встречаются у больных ВИЧ, могут быть признаками гиповитаминоза, дисбактериоза или же последствием приема антибиотиков у человека, не являющегося носителем ВИЧ-инфекции.
Какие беспокоят симптомы?
Чаще всего Candida поражает слизистые оболочки тела — рот, гениталии, также может развиваться в уголках рта, провоцируя ангулярный хейлит, в складках кожи — под грудью у женщин, в подмышечных и ягодичных складках, в промежности и даже в межпальцевых складках на руках. Более редким является проявление грибка рода Candida на гладкой коже. Симптоматика болезни приведена в таблице:
| Разновидность кандидоза | Характерные симптомы |
| Кандидоз рта | Проявляется белым налетом на языке, дужках неба и слизистой щек. Возможны болезненные ощущения при приеме пищи, ощущение жжения во рту. |
| Молочница у женщин | Регулярные творожистые выделения, зуд, болевые ощущения во время секса, дискомфорт при мочеиспускании, неприятный запах. |
| Кандидный хейлит | Болезненные трещины (заеды) в уголках рта, покрытые белесым налетом, который легко снимается. |
| Кандидоз складок | Проявляется эрозиями малинового цвета, могут иметь синеватый оттенок и шелушение кожи по краям. |
| Кандидоз гладкой кожи | Проявляется так же, как и кандидоз складок и, обычно, является его последствием. |
Особенность течения
Кандидоз у ВИЧ-инфицированных зачастую образуется в ротовой полости. Позже может проявляться кандидным хейлитом. У зараженных СПИДом грибок склонен к быстрому развитию, рецидивам и проявлению явных симптомов болезни в краткие сроки. Изо рта может очень быстро перейти в пищевод и вызвать проблемы с пищеварением, вплоть до перекрытия пищеварительных путей из-за отека слизистой оболочки. Также для больных СПИДом характерны атипичные формы грибка. К примеру — фолликулит, который может вызвать язвы на месте фолликул, а позже — частичное облысение.

Кандидоз в данном сочетании, редко излечим из-за слабого иммунитета.
Особенности течения у ВИЧ-инфицированных:
- У мужчин с ВИЧ появляется чаще, нежели у женщин.
- Лечение редко приносит результаты.
- Кандидоз полости рта при ВИЧ встречается в 20% случаев, реже — в генитальных и перигенитальных зонах.
- Проявления хейлита распространяются быстрее и с высокой интенсивностью.
- У ВИЧ-инфицированных возможно развитие атипичных штаммов грибка.
Диагностика кандидоза при ВИЧ
При наличии явных симптомов проводится ряд анализов на наличие грибков рода Candida. В первую очередь проводят выявление грибов в крови и мочи. Это помогает определить, насколько организм поражен грибком. Также берется мазок зева и прочих пораженных слизистых тканей. Могут забираться пробы кожи, ногтей. Серологические реакции у ВИЧ-инфицированных остаются отрицательными, поэтому диагностическое значение имеют выделение грибка из спинномозговой, внутрисуставной жидкостях и крови. После забора материала производится посев, позволяющий определить вид и род грибка, а также количество патогенных микроорганизмов микрофлоры.
Какое показано лечение?
Кандидоз – это грибковое заболевание (микоз), причиной которого являются дрожжеподобные грибки рода Candida. Отличительная особенность таких грибков заключается в том, что они всегда присутствуют в человеческом организме в относительно небольших количествах, так как составляют часть нормальной микрофлоры. Однако в некоторых случаях происходит значительно увеличение их популяции (что часто свидетельствует о снижении иммунитета) – тогда и развивается кандидоз.
Симптомы кандидоза
Проявления кандидоза зависят в первую очередь от того, где именно локализуется очаг инфекции. Выделяют поверхностные кандидозы (с поражением кожи, ногтей, слизистых оболочек) и системные (поражение слизистых и подслизистых оболочек внутренних органов).
В свою очередь поверхностные кандидозы подразделяются на:
- онихомикоз (грибковое поражение ногтя и ногтевого валика);
- кандидоз гладкой кожи;
- кандидоз слизистых оболочек (орофарингеальный кандидамикоз, кандидамикозный хейлит, кандидозный вульвовагинит у женщин, баланит/баланопостит у мужчин).
При дрожжевых поражениях ногтя наблюдается покраснение ногтевых валиков, их отечность, болезненность кожи вокруг ногтя.
Кандидамикоз гладкой кожи начинается обычно с крупных складок, где создаются наиболее благоприятные условия для размножения грибков (влажность и тепло). Поражения кожи грибками Candida может проявляться очагами эрозии с мокнутием, а также возникновением многочисленных пузырьков.
При кандидозе влагалища (кандидозный вульвовагинит) больная ощущает жжение и зуд, которые особенно усиливаются после гигиенических процедур, после мочеиспускания и полового акта.
Острая форма кандидозного вульвовагинита сопровождается гиперемией и отечностью слизистых оболочек влагалища, выделениями творожистого характера с неприятным запахом. После перехода заболевания в хроническую форму творожистые выделения становятся скудными либо вообще исчезают, однако покраснение слизистых оболочек и ощущение дискомфорта во влагалище (иногда чувство распирания) сохраняются.
При кандидозе наружных половых органов у мужчин поражения проявляются эрозиями на головке полового члена, характерными красными пятнами, отечностью.
Без лечения у женщин грибковая инфекция влагалища может способствовать развитию инфекций органов таза, а у беременных вызывать осложнения беременности и родов.
В редких случаях и у мужчин, и у женщин поражения слизистой оболочки половых органов может привести к развитию уретрита и даже цистита с симптомами, характерными для каждой из патологий: рези в уретре при мочеиспускании или боли в нижней части живота.
Очень часто кандидозная инфекция поражает слизистую оболочку рта, что особенно характерно для детей первого года жизни. Главным симптомом орофарингеального кандидамикоза является густой белый налет на языке, внутренней поверхности щек, на небных миндалинах и в глотке.
При кандидамикозе кишечника, который чаще всего является следствием приема антибиотиков, у больного наблюдается метеоризм, диарея, а в стуле имеются примеси беловатого цвета. Нередко кандидамикоз кишечника проявляется периодически возникающими болями в области живота.
Кандидоз: диагностика и лечение
Для постановки диагноза при кандидозе полости рта или кожи используются как визуальные, так и лабораторные методы диагностики. Однако решающее значение при постановке диагноза имеет прямая микроскопия и бакпосев. В последнем случае можно также проверить чувствительность патогена к разнообразным противогрибковым препаратам.
В последние годы кроме названных методов для диагностики кандидоза также применяют иммуноферментный анализ и ПЦР (полимеразная цепная реакция).
При легком течении кандидоза назначают препараты местного действия (кремы, мази, суппозитории), содержащие противогрибковые вещества. При кандидозном стоматите хороший эффект обеспечивают и регулярные полоскания рта растворами с противогрибковыми агентами.
Хроническое или рецидивирующее течение кандидоза предполагает назначение системных препаратов для приема внутрь. В подобных случаях также необходимо комплексное диагностическое обследование, так как упорная грибковая инфекция может свидетельствовать об эндокринных нарушениях, болезнях кишечника или опухолях.
В последнее время как вспомогательный метод терапии практикуется назначение бактериальных препаратов, которые обеспечивают увеличение в организме численности полезных микроорганизмов (например, молочнокислых бактерий), которые являются естественными конкурентами грибков.
Кандидоз: причины и формы
В определенных условиях эффективность работы иммунной системы может снижаться, что приводит к усиленному размножению грибков Candida, относящихся к номрофлоре, и развитию кандидоза.
В зависимости от того, какая разновидность иммунитета (местный или общий) снизила свою эффективность, массовое размножение таких дрожжеподобных грибков происходит либо на поверхности тканей (кожи, ногтей, слизистой оболочки ротовой полости, влагалища, мужских подовых органов, уретры), либо в слизистой оболочке кишечника и других внутренних органов.
Чаще наблюдается локализованное развитие грибков Candida на слизистой рта либо на слизистой влагалища у женщин, причиной которого является длительное или неправильное лечение антибиотиками. Антибактериальные средства не обладают избирательным действием – они действуют в одинаковой мере пагубно не только на патогенные бактерии (к примеру, сальмонеллы, стрептококки или стафилококки), но и на полезные, являющиеся необходимым компонентом микробиоты здорового человека.
Кроме антибиотикотерапии существуют и другие факторы риска развития кандидоза:
- воспалительные заболевания женской и мужской половой сферы, включая ЗППП;
- эндокринные заболевания (сахарный диабет, болезни щитовидной железы);
- химиотерапия рака;
- длительный прием кортикостероидов;
- ношение зубных протезов;
- авитаминоз;
- гипергидроз (повышенная потливость);
- одежда из синтетики (носки, чулки, нижнее белье).
Есть также данные, что прием средств для пероральной контрацепции может стать причиной развития кандидозного вульвовагинита у женщин.
Кандидоз при ВИЧ – одна из распространенных инфекций, которая чаще всего поражает полость рта. При иммунодефиците патология имеет ряд особенностей, так как патогенные микроорганизмы активно развиваются на фоне ослабленного иммунитета.

Формы заболевания
Кандидоз при наличии ВИЧ-инфекции развивается на второй стадии заболевания. Грибки кандида, которые являются возбудителем, стремительно развиваются на слизистых оболочках полости рта, влагалища. Патологический процесс проявляется в виде белого налета, слой которого быстро увеличивается. Удалить его достаточно затруднительно, а с течением времени появляется боль и жжение.
Патологический процесс может локализоваться на:
- верхнем небе;
- гортани;
- ротовой полости;
- пищеводе;
- деснах.
При отсутствии терапии кандидоз во рту проявляется в виде налета, очаг которого слегка возвышается над поверхностью слизистой. Они сливаются и образуют пятно большого размера. По внешнему виду оно напоминает проявление красного лишая.
На слизистой неба чаще локализуется гиперпластическая форма, которая отличается стремительным развитием у курильщиков. Образованный налет легко удаляется и локализуется в уголках рта.
Патологический процесс становится причиной появления трещин, которые длительное время не заживают и покрываются налетом серого цвета. Отсутствие терапии приводит к увеличению области поражения. Данная форма сопровождается болезненными ощущениями. Эритерматозная форма характеризуется формированием налета на языке. Патологический процесс локализуется на средней спинке органа. Основным симптомом является атрофия сосочков языка.
Кандидоз у ВИЧ-инфицированных может иметь классические симптомы молочницы. Проявляется зудом, жжением и появлением обильных выделений из влагалища. При мочеиспускании также возникают дискомфорт и болезненные ощущения.
Признаки молочницы при вирусе иммунодефицита
Симптомы заболевания при наличии ВИЧ-инфекции зависят от стадии и формы патологии. Кандидоз, развивающийся в полости рта, проявляется болью в горле, нарушением вкусовых ощущений и затрудненным глотанием. Среди внешних признаков наблюдаются красные пятна на поверхности языка, слизистой горла.
При молочнице пищевода внешние проявления полностью отсутствуют. Пациенты жалуются на боли в области груди, возникающие при проглатывании пищи. Признаки характерны только при кандидозе, который развивается на фоне ВИЧ-инфекции.
Вагинальный кандидоз отличается наличием белых выделений из влагалища творожистой консистенции. Они сопровождаются жжением и зудом различной интенсивности. На поверхности кожного покрова наблюдаются высыпания.
Кандидоз при ВИЧ встречается значительно чаще, чем у здоровых женщин с отрицательным результатом анализов.
Грибки Candida и вирус иммунодефицита человека
Грибки кандида – одноклеточный микроорганизм, который присутствует в организме любого человека. Но при положительном ВИЧ-статусе лабораторное исследование на наличие кандидоза может показывать отрицательный результат. Основным признаком заболевания является наличие налета на слизистых полости рта.
Молочница при иммунодефиците диагностируется значительно чаще, что обусловлено сниженным иммунитетом. Именно поэтому патология отмечается уже на начальных стадиях развития инфекции.
Лечение кандидоза у пациентов с ВИЧ
Пациентам следует знать, что при наличии ВИЧ-инфекции заниматься самолечением категорически запрещено. Это может стать причиной серьезных последствий и осложнений.

В первую очередь важно устранить причину появления патогенных микроорганизмов. Специалисты рекомендуют увеличить количество витамина В, который поможет поддержать иммунитет.
При поражении кожного покрова назначаются антимиотические препараты в виде мазей и кремов. Лекарства местного воздействия оказывают влияние непосредственно на очаг патологического процесса, ускоряя процесс выздоровления. При поражении слизистых оболочек полости рта терапия предполагает использование медикаментов в виде суспензии, таблеток или инъекций.
Курс зависит от типа и количества микроорганизмов и назначается лечащим врачом. Также учитываются стадия ВИЧ-инфекции и состояния пациента. В некоторых случаях может быть назначен амфотерицин в виде инъекций.
Больным также назначается специальная диета, которая предполагает исключение жирной, жареной, соленой и острой пищи. Она раздражает не только кишечник, но и пораженную слизистую полости рта. Пища не должна быть слишком горячей или холодной. В рацион необходимо ввести большее количество фруктов и овощей. В их состав входят витамины и минеральные вещества, помогающие поддержать иммунитет.
Чем опасен и последствия
При отсутствии терапии заболевание переходит в запущенную стадию. При этом возрастает риск перехода ВИЧ на фоне молочницы в СПИД. В этот период наблюдается увеличение лимфатических узлов и развитие раковых инфекционных заболеваний.
Антиретровирусная инфекция при поражении слизистой полости рта при иммунодефиците проявляется на ранних стадиях. Возможно проведение лечения, которое назначает врач. Прогноз при этом более благоприятный и продлить жизнь пациента помогут противогрибковые препараты.
Кандидоз при ВИЧ отличается более агрессивным течением. Но на начальных стадиях развития лабораторные исследования не устанавливают наличие бактерий в организме. Определить кандидоз можно по характерным симптомам. Пациентам необходимо незамедлительно начинать лечение, так как при отсутствии терапии развиваются серьезные осложнения. Именно поэтому следует своевременно обращаться к врачу и следовать всем рекомендациям специалиста.

Красивые и ухоженные руки – залог гордости каждого человека. Но регулярный уход не всегда способен защитить руки от дерматологических заболеваний.
Иногда их могут поразить грибки рода Кандида. Ногти становятся рассадниками микроорганизмов.
В результате развивается кандидоз ногтей – довольно распространенное заболевание.
Что это такое
Кандидоз ногтей – неприятное заболевание, вызванное грибками Candida. Микроорганизмы начинают размножаться на ногтевых пластинах и вызывают воспалительные процессы. Во время заболевания страдает ноготь, околоногтевой валик и кожица. Болезнь поддается лечению, но если ее игнорировать, то она перейдет в хроническую форму.
ФАКТ: Болеют данным видом кандидоза чаще женщины.
Причины болезни

Грибки кандида присутствуют в каждом организме, но в небольшом количестве. Снижение иммунитета ведет к резкому размножению микроорганизмов.
Они могут локализоваться на кожных покровах, слизистых оболочках, ногтях.
Развитие кандидоза ногтей провоцируется следующими факторами:
- постоянная работа в воде – грибки активно размножаются во влажной среде. Если человек долго контактирует с жидкостями, то он входит в группу повышенного риска;
- беременность и кормление грудью;
- любые хронические заболевания;
- несоблюдение личной гигиены рук;
- травмы на коже – это могут быть любые повреждения (трещины, ссадины, порезы);
- долгий прием антибиотиков – препараты должны быть прописаны врачом, наряду с ними следует принимать препараты, нормализующие микрофлору в кишечнике;
- дисбактериоз.
Грибок передается от человека другому человеку, если не соблюдать правила гигиены.
Можно заразиться и при небольших травмах острыми инструментами (маникюрными ножничками или пилочкой).
Внимание! Обычно заражение происходит в общих банях, саунах, душевых – местах с высокой влажностью.
Симптомы
Заболевание имеет ярко выраженные признаки, болезнь проходит поэтапно. Фото кандидоза ногтей приведено ниже.
1. Первый этап называется кандидозная паронихия. В это время воспаляется околоногтевой валик. Кожа вокруг ногтей краснеет и опухает. При контакте с любыми жидкостями или предметами человек ощущает болезненность. Иногда на пальцах появляются трещинки или эрозии. Также прекращает расти ногтевая кожица. При надавливании на ноготь может выделяться гной.
2. На втором этапе развивается онохомикоз. Поражается сам ноготь – становится мутным и тусклым. Ногтевая пластина может крошиться или ломаться. В то же время припухлость кожи исчезает.
3. На последнем этапе ноготь становится желто-коричневого оттенка (иногда серо-желтого). Ногтевая пластина утолщается, в то же время она постоянно крошится. Кровоснабжение ногтя ухудшается, что приводит к его постепенному отмиранию. Со временем он отпадает.




Профилактика
Кандидоз развивается из-за снижения иммунитета, поэтому необходимо постоянно поддерживать иммунную систему. В рационе должны присутствовать все необходимые элементы, стоит регулярно пропивать курс витаминов, отказаться от вредных привычек.
Людям, находящимся в группе риска, следует уделять гигиене рук особенное внимание. После длительного контакта с водой следует тщательно вымыть руки с мылом и вытереть кожу. При наличии трещин, микротравм на руках стоит работать в резиновых перчатках.

Перед тем как делать маникюр в салоне, убедитесь, что инструменты были продезинфицированы.
По возможности пользуйтесь личным маникюрным набором.
Соблюдение профилактических мер гораздо легче и доступнее, чем лечить кандидоз ногтя в дальнейшем.
Диагностика
При первых признаках заболевания стоит обратиться к дерматологу. Первоначально доктор проводит визуальный осмотр, выслушивает жалобы пациента. Для постановки верного диагноза он назначает ряд лабораторных исследований:
- общий анализ крови – поможет исключить аллергию или бактериальную инфекцию;
- микроскопия биологического материала, взятого с ногтевой пластины – анализ определит наличие грибков кандида.
На основе полученных данных врач ставит диагноз. Иногда может быть проведено бактериологическое исследование (посев, выявляющий колонии микроорганизмов).
Как лечить кандидоз ногтей
Врач-дерматолог выписывает препараты, направленные на борьбу с грибками. Помимо этого пациенту следует укрепить иммунитет (можно пропить курс витаминов). При наличии хронических заболеваний терапия кандидоза должна сочетаться с основным лечением.

Степень заболевания определяет врач. В случае необходимости ноготь будет удален целиком или частично. Это позволит открыть ложе, в котором содержатся возбудители заболевания.
Лечение состоит из следующих этапов:
При соблюдении всех рекомендаций врач прогноз лечения всегда благоприятный. Кандидоз ногтей исчезает полностью, а на месте поражения вырастает здоровый ноготь. Но если затягивать с терапией, то болезнь перейдет в хроническую форму, требующую совершенно другого подхода.
Внимание! Во время лечения рекомендуется соблюдать особую диету. В рацион включить больше блюд, богатых кальцием. Максимально ограничить сладкое и мучное.
Народные методы

Кандидоз ногтей известен с давних времен. Раньше его лечили народными рецептами. Их можно применять и сейчас, но народная медицина должна дополнять медикаментозное лечение.
В противном случае может наступить недолгое облегчение, но грибок так и останется в организме. При первом удобном случае (болезнь, травма рук) болезнь опять начнет свое развитие.
- Втирайте в ногти дважды в сутки эфирное масло чайного дерева. Продолжительность лечения составляет три месяца.
- Помочь в лечении может прополис. Намочите ватный или марлевый тампон в двадцатипроцентном растворе прополиса. Приложите его на пораженный участок и держите три минуты. Уберите тампон и подождите, пока ногти высохнут естественным образом.
Продолжайте лечение, пока грибок не исчезнет.
Возможные осложнения
Кандидоз на ногтях отличается вялым течением. Больные поначалу не обращают внимания на заболевание и поздно обращаются к врачу. За это время могут развиться осложнения:
- к грибку присоединяется еще и бактериальная инфекция;
- ногтевая пластина поражается целиком и врачу придется удалять весь ноготь;
- заболевание переходит в хроническую форму.
Кандидоз ногтей у детей

Заболевание встречается и у малышей. Это связано с тем, что они часто пренебрегают гигиеной рук и травмируются.
Симптоматика заболевания аналогична со взрослыми людьми. Поначалу страдает околоногтевой валик, кожа начинает шелушиться. Затем ноготь слоится и крошится. При надавливании из него может выходить гной.
Лечение назначает детский дерматолог, исходя из возраста пациента. Главные препараты – лекарственные средства противогрибкового действия. Лечащий врач подберет наиболее оптимальный вариант, который поможет вылечить кандидоз ногтей у ребенка. На первых стадиях будет достаточно использовать крема или гели. При необходимости будут прописаны таблетки.
Как быстро вылечить грибок
После начала терапии симптомы начнут постепенно исчезать и станут меньше беспокоить. Но для полного излечения придется пройти весь курс лечения. Если прекратить терапию при первом улучшении, то заболевание вернется и начнет прогрессировать.
Болезнь не поддается быстрому лечению, но противогрибковые препараты значительно уменьшат признаки и улучшат самочувствие больного.

Кандидоз – это разновидность грибковой инфекции. Говорят, что грибы кандида дрожжеподобные. Но не стоит проводить аналогию между дрожжами для приготовления хлеба, кваса, пива и микроорганизмами рода Кандида.
Микроскопические грибы живут на слизистой поверхности практически всех органов человека. Причем чаще с самого рождения. Но создают проблемы только в определенных условиях (условно-патогенная флора). Когда человек здоров – их воздействие на организм не ощущается.
Часто грибы Кандида называют несовершенными грибами. Среди грибов существует деление на классы – совершенные и несовершенные. Такое деление связано со способом размножения – половое и вегетативное. Грибы Кандида размножаются вегетативно (как растения). Поэтому и относятся к классу несовершенных грибов.
Кандидоз – что это
Кандидоз – это разновидность грибковой инфекции, вызываемая микроскопическим дрожжеподобным грибком рода Кандида.
Справочно. Заболевание проявляется появлением специфического беловато-желтого налета, похожего на творог, поэтому кандидоз часто называют молочницей.
В зависимости от локализации и тяжести кандидоза, лечением может заниматься:
- неонатолог – кандидоз полости рта у новорожденных;
- инфекционист – молочница ротовой полости у взрослых, кандидоз кишечника, генерализованные формы кандидоза;
- иммунолог – системные кандидозы на фоне ВИЧ-инфекции;
- гинеколог – вагинальный и урогенитальный кандидоз;
- дерматовенеролог – кандидоз кожи и ногтей (также может лечить вагинальный и урогенитальный кандидоз, кандидозные баланопоститы у мужчин).
Кандидоз – причины
Кандидоз вызывается грибками рода Кандида. Это несовершенные дейтеромицеты (анаскоспоровые грибки). Основными возбудителями кандидоза являются – Candida albicans, Candida non-albicans и Candida tropicalis.
В норме, Candida albicans относится к условно-патогенным микроорганизмам и входит в состав естественной микрофлоры кишечника и влагалища.
Справочно. При снижении иммунитета, нарушении кишечной или влагалищной микрофлоры грибки рода Кандида начинают усиленно размножаться и приводят к развитию воспалительного процесса.
У пациентов с иммунодефицитом кандидоз может протекать в генерализованной форме, приводя к язвенному поражению слизистых желудочно-кишечного тракта, нарушению функции почек, развитию диссеминированного – внутрисосудистого свертывания крови, кандидозного сепсиса.
Большинство людей заражается грибками Кандида внутриутробно (грибок может обнаруживаться в околоплодных водах, пуповинных оболочках), при прохождении родовых путей матери или в первый год жизни.
При нормальном иммунитете, а также при отсутствии нарушения естественной микрофлоры грибок Кандида не вызывает воспалительных процессов и не приводит к развитию кандидоза (молочницы).
Факторами риска развития кандидоза являются:
- нарушение естественной микрофлоры ротовой полости, кишечника, мочеполового тракта, влагалища;
- снижение иммунитета;
- сухость влагалища у женщин;
- частые спринцевания;
- использование агрессивных порошков при стирке белья;
- наличие у пациента сахарного диабета (часто проявляется рецидивирующим хроническим кандидозом);
- беременность;
- прием цитостатических или антибактериальных препаратов, глюкокортикоидов, иммунодепрессантов;
- менструации (у женщин влагалищный кандидоз часто обостряется перед месячными).
Наиболее частой причиной развития влагалищного кандидоза у женщин является прием антибактериальных препаратов (особенно пенициллинов). Прием антибиотиков приводит к нарушению естественной микрофлоры влагалища и развитию кандидоза.
Длительный прием антибактериальных препаратов также может спровоцировать развитие кандидоза кишечника и ротовой полости. 
У детей кандидоз во рту часто развивается, если мать принимает антибиотики во время грудного вскармливания. Также кандидоз ротовой полости может наблюдаться у недоношенных детей или при недостаточной стерилизации сосок-пустышек. При развитии кандидоза на фоне искусственного вскармливания следует рассмотреть вопрос о переводе ребенка на другую смесь.
Кандидоз у мужчин, сопровождающийся развитием баланопостита, может возникать после полового контакта с партнершей с острым влагалищным кандидозом. Кандидозу половых органов у мужчин часто сопутствуют другие инфекции, передающиеся половым путем (хламидиоз, трихомоноз).
Читайте также:


